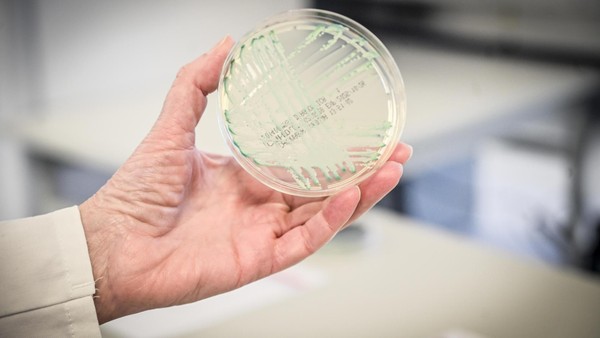

Veterinäramt warnt: Herne liegt in Gefahrenzone von Seuche – Impfung empfohlen
Das Veterinäramt warnt Tierhalter wegen einer sich ausbreitenden Tierseuche. Es gibt strenge Regeln. Und eine Impfung wird dringend empfohlen.
Das Veterinäramt warnt Tierhalter wegen einer sich ausbreitenden Tierseuche. Es gibt strenge Regeln. Und eine Impfung wird dringend empfohlen.